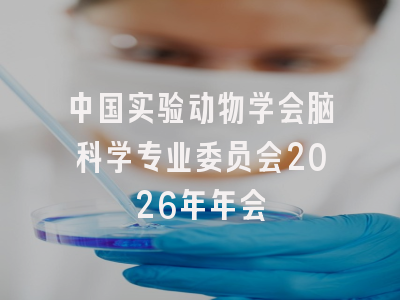
中国实验动物学会脑科学专业委员会2026年年会

中国实验动物学会脑科学专业委员会2026年年会
会议名称
中国实验动物学会脑科学专业委员会2026年年会
会议时间
2026-04-10 – 2026-04-12
举办城市
内蒙古-呼和浩特
会场地址
内蒙古乌澜大酒店(内蒙古呼和浩特赛罕区如意开发区如意和大街58号)
主办单位
中国实验动物学会脑科学专业委员会
承办单位
内蒙古医科大学,会议主题 聚焦生物医药前沿与区域健康需求,推动学科建设与产业发展深度融合,会议介绍
关于举办中国实验动物学会脑科学专业委员会2026年年会的通知
尊敬的专家学者:
由中国实验动物学会脑科学专业委员会主办、内蒙古医科大学承办的“中国实验动物学会脑科学专业委员会2026年年会”将于2026年4月10-12日在内蒙古自治区呼和浩特市召开。本届年会围绕生物医药前沿技术研发与区域健康发展核心需求,聚焦脑科学、干细胞与再生医学等重点领域,推动学科建设、技术创新与产业发展深度融合,助力区域医疗卫生服务体系与生物医药产业高质量发展。大会将邀请领域内著名专家学者和青年学者作会议报告。
欢迎相关领域老师和学生积极参会!
一、会议主题:聚焦生物医药前沿与区域健康需求,推动学科建设与产业发展深度融合。
二、主办单位:中国实验动物学会脑科学专业委员会
三、承办单位:内蒙古医科大学
四、大会组织机构
会议名誉主席:秦 川(中国实验动物学会副理事长)
张 晨(内蒙古医科大学校长、中国实验动物学会
脑科学专业委员会主任委员)
会议主席:贾永峰(内蒙古医科大学党委委员、副校长)
焦建伟(中国实验动物学会脑科学专业委员会副主任委员)
执行主席:薛明明(内蒙古医科大学党委委员、副校长)
柴人杰(中国实验动物学会脑科学专业委员会常务委员)
秘书长:董 玉(内蒙古医科大学科研处处长)
侯春雷(内蒙古医科大学第二附属医院学术副院长)
五、会议时间及地点:2026年4月10-12日,内蒙古乌澜大酒店(内蒙古呼和浩特赛罕区如意开发区如意和大街58号)。
六、会议日程:
|
序号 |
时间 |
内容 |
|
1 |
4月10日全天 |
大会报到 |
|
2 |
4月10日下午 |
青年论坛 |
|
3 |
4月11日全天 |
大会主论坛 |
|
4 |
4月12日全天 |
大会主论坛 闭幕式 |
七、拟参会专家(按姓名拼音顺序排列):柴人杰、陈 林、陈 鹏、陈万金、程金科、程 涛、程 辉、丁楅森、丁俊军、杜 鹏、冯 瑾、冯世庆、付小龙、高亚威、高绍荣、高 帅、高钰琪、顾 宁、郭俊莉、郭 兴、贺祖宏、何爱彬、胡 霁、惠利健、侯春雷、贾顺姬、焦建伟、金子兵、蒋琳加、蒋 卫、兰 峰、李 龙、李 明、李天晴、李文研、李校堃、李 勇、梁倩倩、梁会营、刘 兵、刘光慧、刘会生、柳素玲、刘文强、刘 妍、刘耀波、刘 真、陆 巍、罗高兴、罗雄剑、米 达、钱鹏旭、曲宜波、潘秉兴、潘玉峰、裴端卿、彭 勃、彭 军、彭小忠、饶 燏、邵 玥、邵志成、沈 贤、时 雨、施国平、史冬泉、孙金鹏、陶 伟、王昌河、王广基、王 兰、王天云、王以政、王 韵、汪秀星、吴海涛、项 鹏、肖国芝、谢敬敦、谢 欣、徐志刚、杨 巍、余 佳、于乐谦、袁 凯、袁 泉、袁增强、岳 锐、张 晨、张宏权、张 勇、章小清、张振涛、赵建国、赵小阳、朱景宁、朱融融、邹卫国。
八、注册费用:本次会议收取注册费,具体费用如下。
|
2026年3月25日前注册 |
2023年3月26日-现场注册 |
|
|
中国实验动物学会会员 |
1000元 |
1200元 |
|
非中国实验动物学会会员 |
1200元 |
1400元 |
|
在校学生 |
600元 |
800元 |
已缴费的参会代表如因故无法出席,恕不办理退款。大会统一安排食宿,费用自理。
1、请扫描右侧二维码填写报名信息。
2、会议费付款方式如下:
(1)银行汇款:
请务必在汇款附言处注明:“脑科学年会+参会人员姓名+手机号码”。
(2)支付宝缴费:
1.持公务卡或其他银行卡的个人将银行卡与本人的支付宝进行绑定;
2.打开持卡人支付宝扫描中国实验动物学会支付宝二维码;
3.进入支付宝付款界面,备注处填写“脑科学年会+参会人员姓名+手机号码”,以方便查收。(注意:此处填写的不是持卡人的信息,而是参会人员信息,需与报名时的信息一致)。
(3)现场缴费:
现场可采取刷卡或扫码缴费,不支持现金缴费。缴费时须提供正确的开票信息(单位全称、纳税人识别号、邮箱地址)。
(4)参会发票:
1.学会将对提前缴纳费用的代表开具电子发票(普通发票),开票项目为“会议费”。须在注册信息表中写明单位财务提供的准确开票信息(单位全称、纳税人识别号)。
2.如未能准确填写开票信息或未提前缴费的代表将不保证按时领取发票。发票将于活动结束后一个月内发送至本人邮箱。
3.强烈推荐参会代表选择非现场提前缴费方式并准确填写会议回执。请准确填写缴费备注信息、汇款留言信息和注册信息,否则不能开具发票。
由于本次会议参会人员较多,请参会人员尽可能提前提交报名信息并确认住宿信息。
九、会议住宿:
本次会议食宿自理,会议期间用餐由会务组统一安排,住宿酒店:
1.内蒙古乌澜大酒店(320元/晚),含早餐。
地址:内蒙古自治区呼和浩特市赛罕区敕勒川路街道如意开发区如意和大街 58 号(内蒙古国际会展中心北侧)
2.美渡酒店(呼和浩特会展中心店)(320元/晚),含早餐。
地址:内蒙古自治区呼和浩特市赛罕区如意和大街 56 号(乌兰财富中心 C 座)
十、会议联系人:
吴七柱,电话:15248093001
王 君,电话:13674716755
Email:immc_kjc@163.com
中国实验动物学会脑科学专业委员会
2026年3月13日
,
,
© 版权声明
本文由分享者转载或发布,内容仅供学习和交流,版权归原文作者所有。如有侵权,请留言联系更正或删除。
相关文章
暂无评论...














